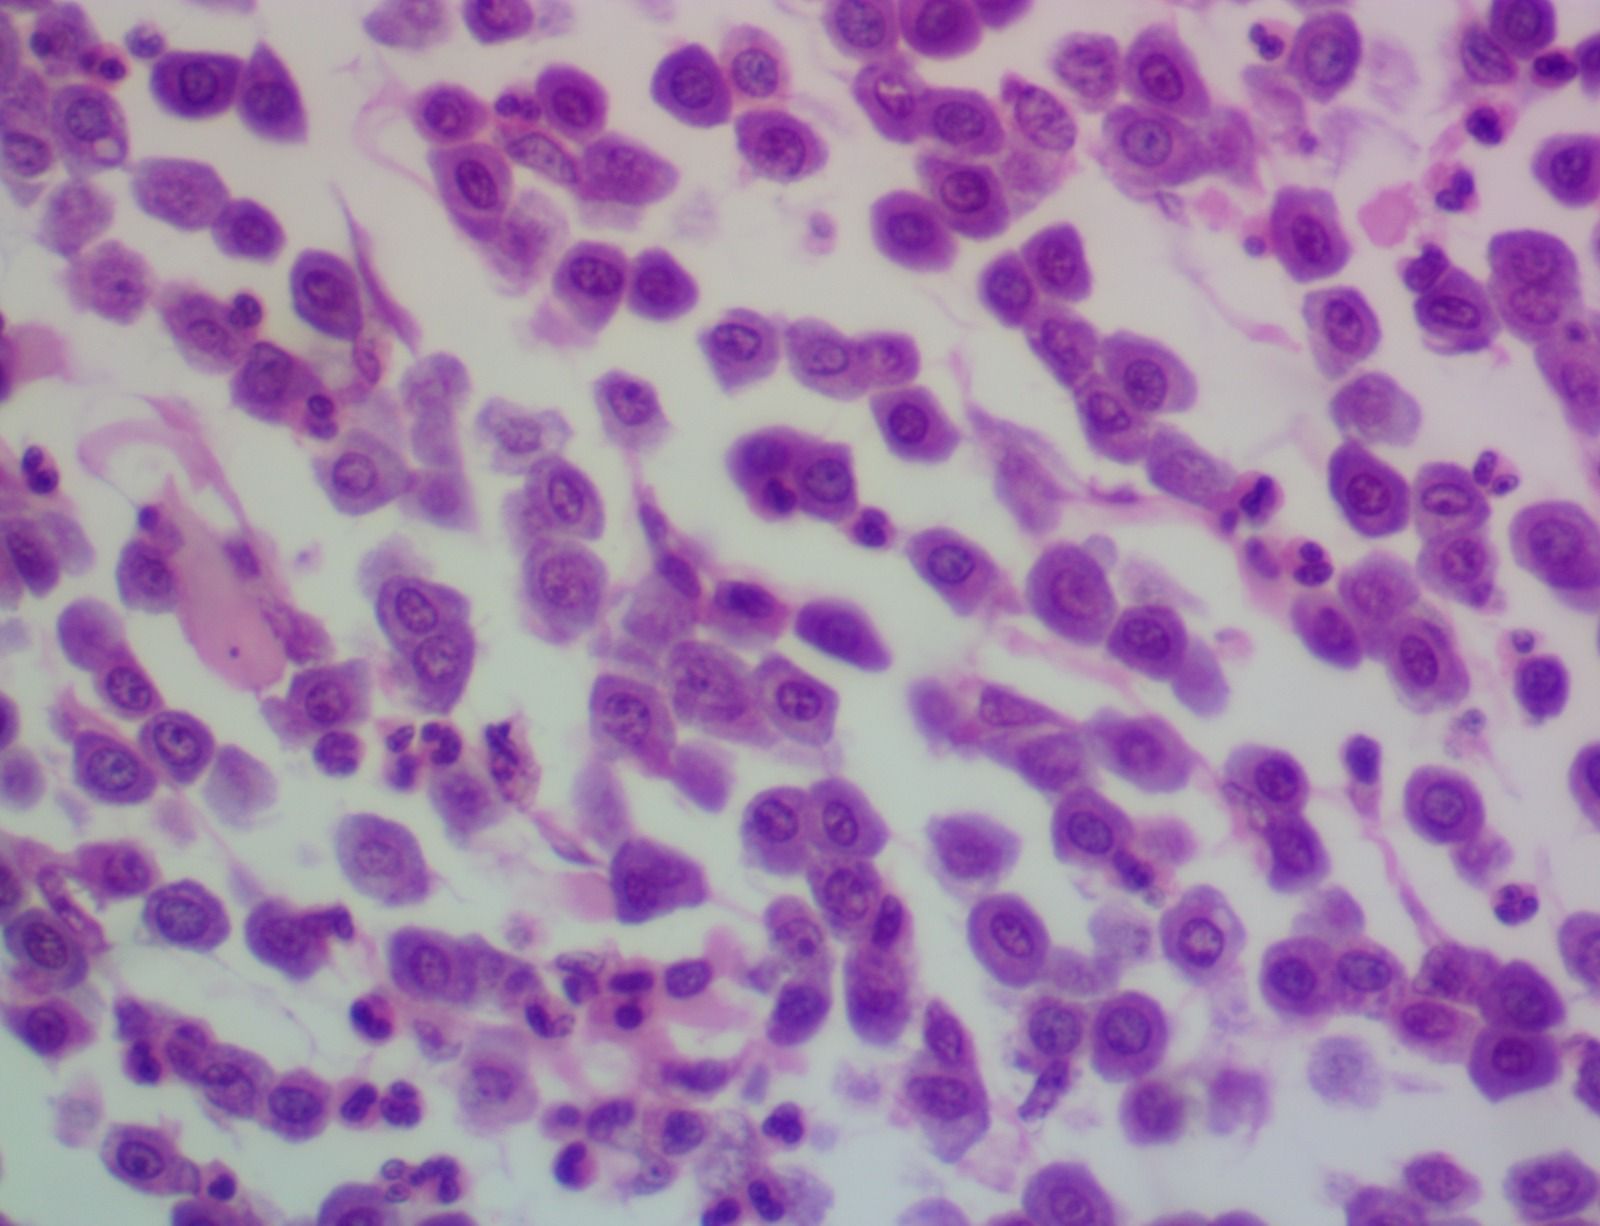
Dx. Patologovet
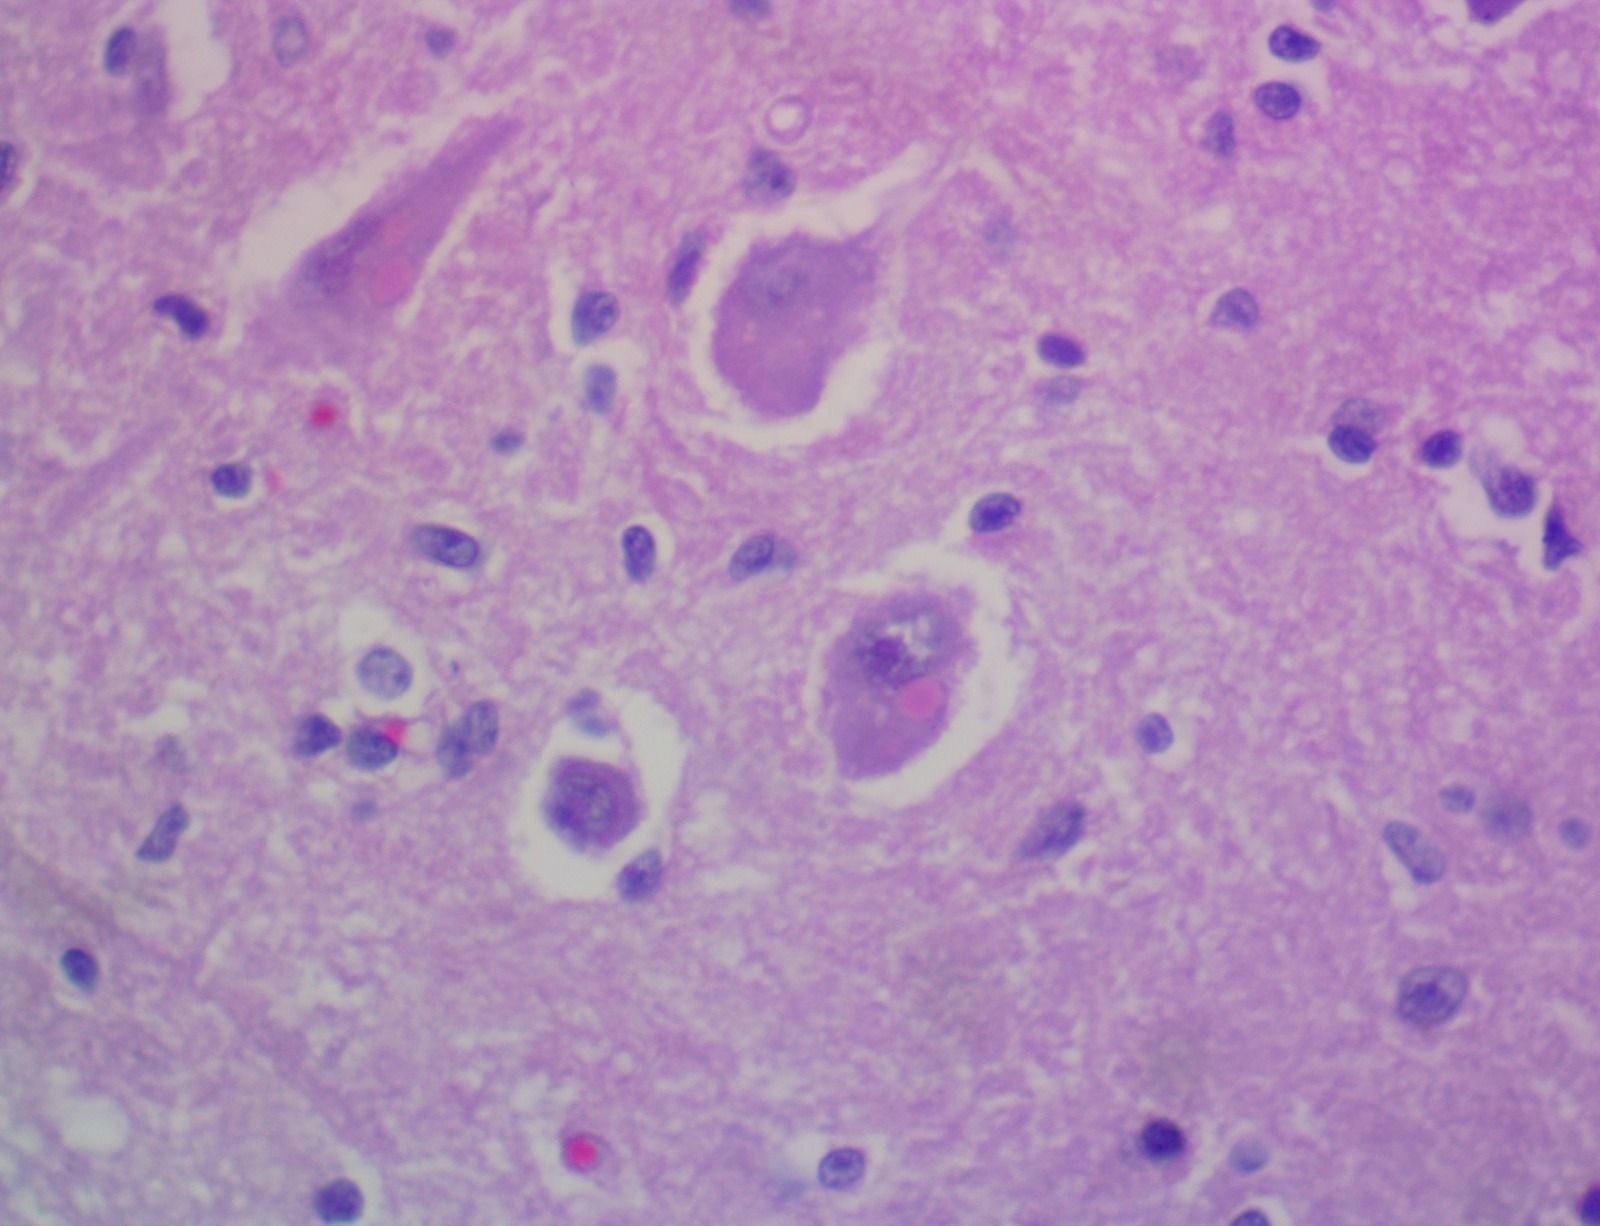
Dx. Patologovet

Especialistas en diagnóstico Histopatológico y Citológico Veterinario.
Especialistas en Dermatopatología y Dermatología Clínica Veterianaria
"No son muestras, son mascotas. El resultado puede ser vida… y está en nuestras manos"
En nuestro Laboratorio de Diagnóstico en Patología Veterinaria.
Nos dedicamos a proporcionar servicios de diagnóstico precisos y confiables para ayudar en la comprensión y tratamiento de diversas condiciones médicas en nuestras mascotas.
Nuestro equipo de patólogos expertos analiza muestras biológicas y proporciona informes detallados fundamentales para la toma de decisiones médicas. Con años de experiencia, tecnología avanzada y un enfoque integral, garantizamos resultados exactos y oportunos. Cumplimos con altos estándares de calidad, tratamos cada muestra con cuidado, atención, trazabilidad, y nos esforzamos por superar las expectativas de médicos y de los pacientes.
Disponemos de equipos especializados para el diagnóstico y tratamiento de enfermedades cutáneas en animales de compañía, ofreciendo un enfoque clínico y patológico integral que garantiza un tratamiento adecuado y efectivo para la salud de la piel de las mascotas.
En nuestra página web, encontrarás información sobre nuestros servicios, equipo de patólogos, especializaciones, recursos educativos y noticias. Estamos comprometidos en brindar un apoyo completo, ayudando a tomar decisiones informadas sobre el cuidado de la salud de las mascotas. Gracias por elegirnos como tu socio en el diagnóstico de patologías.
Misión
Nuestra misión es proporcionar servicios de patología veterinaria de alta calidad para promover la salud y el bienestar animal. Nos comprometemos a ofrecer diagnósticos precisos y oportunos mediante la utilización de técnicas avanzadas y expertos especializados en el área de la patología veterinaria.
Visión
Convertirnos en el laboratorio líder reconocido en el campo de la patología veterinaria, estableciendo estándares de excelencia y contribuyendo al avance de la medicina veterinaria y la protección de la salud humana, animal y del medio ambiente.
Contamos con la mayor experiencia y trayectoria del área.
Nuestros profesionales están en formación continua para dar la mejor atención a cada cliente. Queremos lo mejor para la salud de tu mascota, trabajamos incansablemente priorizando lo mejor para ellos.